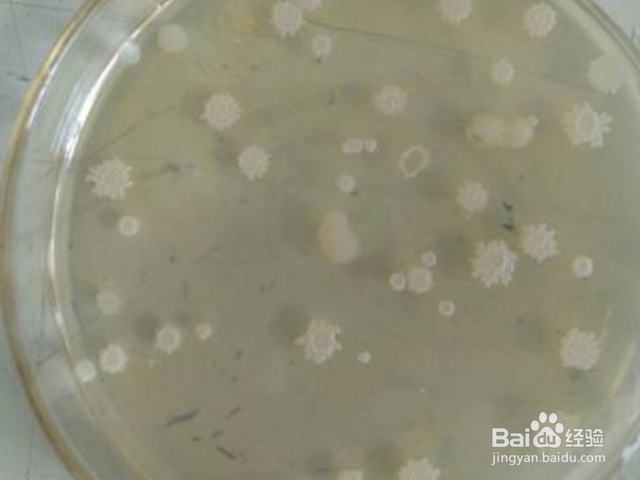
蜡渍怎么去除？

蜡渍怎么去除?
1、 一、将熨斗插入离蜡渍不远的插座。 把熨斗调到最低温度。 如果电熨斗有蒸汽的作用,就把它关掉。 首先,用非锋利的小刀削除可以去除的蜡渍。 (可以在黄油刀的背面擦)等待熨斗预热的时候可以这样做。

2、二、 然后在蜡渍上铺上牛皮纸或纸巾,用电熨斗在纸上横着熨平。 慢慢地移动熨斗,像平时熨烫一样,注意不要把纸和地毯烧焦。 熨斗的热量溶解蜡渍,纸吸收熔化的蜡渍。

3、三、 换张纸,用刚才的方法持续熨烫,直到蜡渍完全被吸收为止。 看看地毯上有没有污迹。 如果地毯上有污迹,则需要用少量的外用酒精擦拭污迹。

4、四、 小心别漏在地板上,别放太多酒精。 继续擦,直到标记消失。 在擦掉的位置上铺上干净的布,在布上压上书和其他重的东西。 这样就可以吸收额外的外用酒精。

5、五、 此方法与前一种方法的基本步骤相似,但需要更多材料。 用冰镇蜡。 把4~5块冰放入塑料袋中,把袋子放在蜡渍上,快要冻僵时除去。 用小刀擦掉多馀的蜡,注意不要损伤地毯。

6、六、用牛皮纸盖上蜡渍。 用打火机把金属汤匙的背面加热5~10秒。 虽然可以用火柴加热,但打火机更方便,更安全,而且火柴的灰也不会落在地毯上。

7、七、 在汤匙还很热的时候,在牛皮纸上涂蜡的地方均匀地涂上汤匙的背面。 我记得涂在蜡上,观察了蜡渍融化的情况。 然后更换牛皮纸,加热汤匙,反复在汤匙背面涂漆的过程。 用外用酒精或洗衣液除去多余的蜡。
声明:本网站引用、摘录或转载内容仅供网站访问者交流或参考,不代表本站立场,如存在版权或非法内容,请联系站长删除,联系邮箱:site.kefu@qq.com。